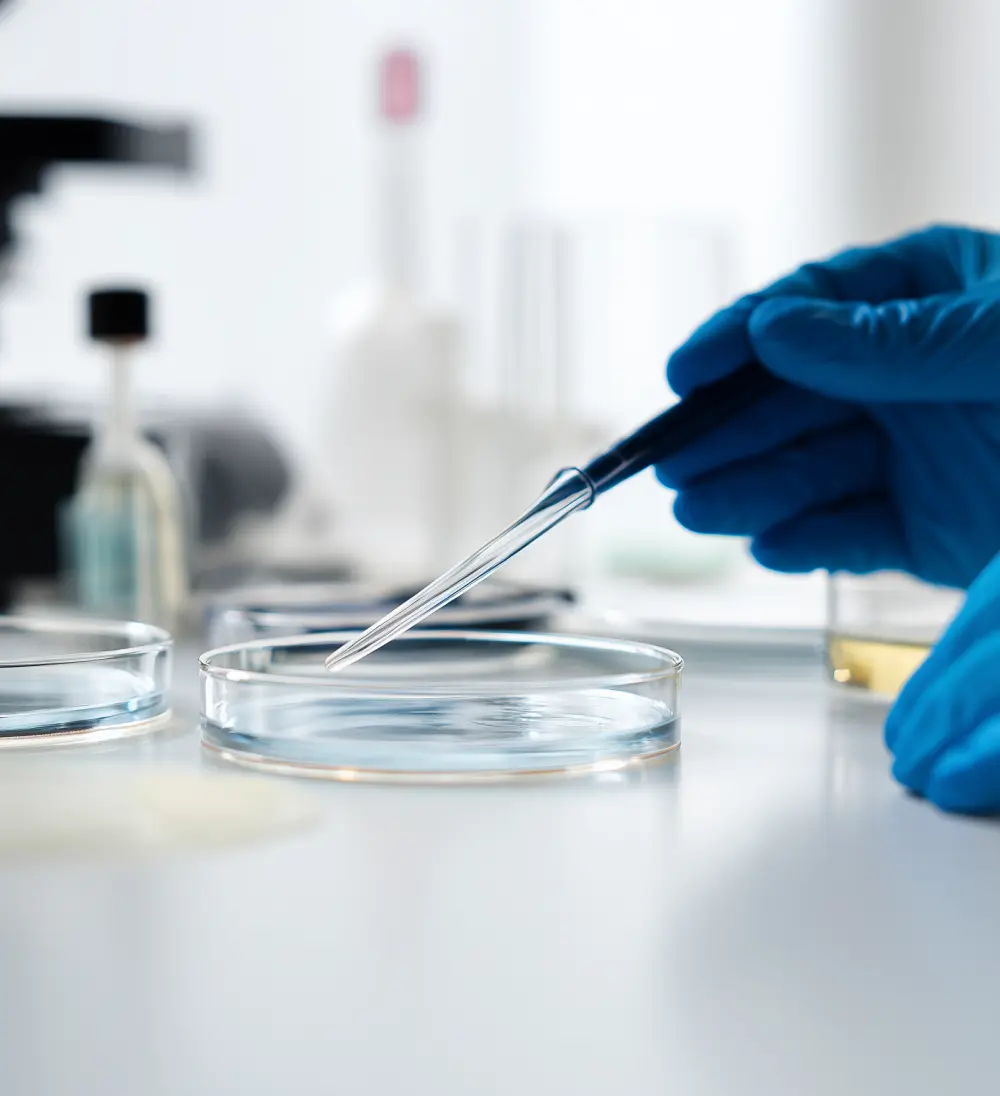

Your trusted global partner in CMC and IND development
We help biotech teams navigate CMC, toxicology, and regulatory strategy. By coordinating the right vendors, we get you to patients faster and with less risk, all through a global network built for execution.

Trusted by the some of the
world’s top organizations





Empowering Drug Development
Streamlined solutions for pharmaceutical success.

Integrated IND Platform
From discovery to submission, one coordinated program.
Toxicology
IND-enabling studies aligned with regulatory requirements.
Discovery
Early-phase biology and chemistry, aligned with your goals.
Biologics
Navigate complex modalities with the right CDMO.
Small Molecule
Get your process optimized and scaled for commercialization with fewer risks.
Drug Product
Formulations that are scalable and manufacturable.
How the Davos model works
With 50+ years of experience, Davos connects you to a trusted global vendor network. Contracting with Davos streamlines management, reduces risk, and ensures one point of accountability — delivering faster timelines, greater efficiency, and confidence your project will succeed.



Unlock your drug development potential
Contact us today to learn how our Integrated IND Platform can streamline your projects.
Latest Insights and News
Explore our latest articles and research findings.